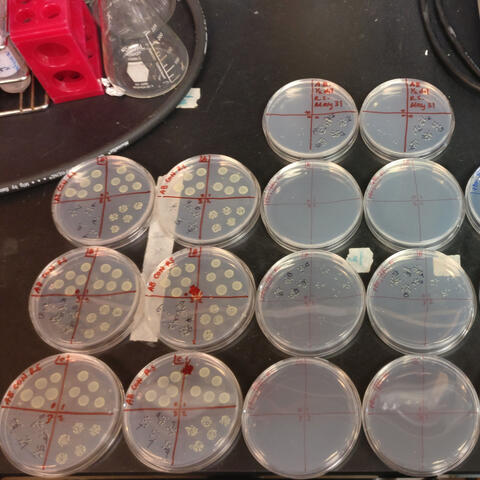
Untitled

Siobhan Renee Liu
OCGC Pharmaceutical Regulatory Affairs & Quality Operations,
Seneca College
B.Sc. (Hons.) Chemistry, Toronto Metropolitan University
Club Advisor, TMU Bold Esports
Guelph/Toronto, Ontario, Canada
They/Them
About
Hey, I'm Siobhan (Any/All)! I am currently a Pharmaceutical Regulatory Affairs & Quality Operations student at Seneca College. I received my Honours Bachelor of Science in Chemistry at Toronto Metropolitan University (formerly Ryerson University) and served as the third President of Ryerson Esports. I have a wide variety of experiences across multiple different professional fields, hence why this CV site is divided up so much. From large-scale event planning to food safety, consumer goods regulations and quality assurance, I have spent a number of years building and refining my skills in team and project management; data collection, entry, analysis, and presentation; creative, academic, and technical writing among many others. I'm very much a jack-of-all-trades, striving to master everything along the way. As an LGBTQ+ in STEM and mental health advocate, my experiences are rather unique and can bring a very different perspective to any project or team. In my free time, I like to photosynthesize while struggling to speak any of the four languages I know. I also like to pretend I'm funnier than I actually am.

「私は私だ!」
Testimonials
Since I'm bad at selling myself, here is a compilation of things other people have said about me! Some of it is serious, others... not so much. Idea taken from my colleague excesstigress.
"Siobhan's introduction was one of the best I have read in many years - clearly written, succinct, engaging."
—My undergraduate thesis supervisor"She is responsible, punctual, and organized. When she is left with a task, she completes it and is easily able to deal with unpredicted problems. Siobhan is able to work with a variety of personality types and always gives clear and concise answers to students in class. She is focused and dedicated and I know I can always count on her."
—My high school chemistry teacher"Ryerson Esports has a new president and for the first time, it’s a woman. But it isn’t a big deal for her."
—A Ryersonian article"Entering her final year as president at the club, that’s not going to stop her from setting up the Esports program for future success."
—An Eyeopener article"MANAGER, I NEED HELP!"
—A former player I used to manage"とても勇敢ですね。(T/L: You are very brave.)"
—My Japanese creative writing editor/translator"I was so scared of you when we first met because I thought you'd tear off my head... Honestly, I still think you will, but only if I really deserve it."
—A friend who is still scared of me"I learned so much from you—especially what not to do in order to succeed."
—One of my mentees
"You were excellent at taking out the pathogen garbage. It helped us out so much when we didn't have anyone to do it during the period where we got rush listeria swabs after rush listeria swabs..."
—A non-direct supervisor at Maple Leaf Foods"I almost don't want to come into work next week because you won't be here. You really helped us in ways that we could have never imagined."
—My direct supervisor at Maple Leaf Foods"If it weren't for you, I would be the only PhD student out there without a single publication. I even thanked you during my defense!"
—The first author of our ACS Applied Bio Materials publication"Thank you for this. You brought my GPA up so much, I never knew it could go that high!"
—Another mentee of mine"You have a gift for learning systems and how they work."
—My supervisor at Reckitt"Oh no, we need to spend money. You're too good at saving it."
—My former VP Finance, Ryerson/TMU Bold Esports"Reading their work is one of the best case scenarios as an editor."
—One of the coordinators for MAL Rewrite"We are strong independent women. We can operate scary freight elevators, we can tell truck drivers to stay off my loading dock, we can survive two moves in two weeks, last but not least, we can chase down the ice cream truck!"
—My supervisor from the Ceremonials Office"I will handcuff myself to you if you do not stop to rest your wrist."
—A friend who stops me from overworking myself
Congratulations! You found a (badly hidden) Easter egg about my self-identity. Perhaps, you're just curious about it and want to learn more. Maybe you're curious, but don't want to Google it. You might be itching to ask me about it too, but don't know if it's crossing any sort of boundaries. This tiny section is dedicated to answering all of those questions!
What is your identity?
I am a biromantic asexual non-binary person of colour. I prefer they/them pronouns in a professional setting.
What is biromantic asexuality?
Biromantic: Romantic attraction to 2 genders.
Asexuality: The sexual orientation in which one lacks/has very little sexual attraction to others.The best way I can describe it is "bisexuality, except without the sex". This is a very generalized term and not all people who identify as a biromantic asexual will generalize themselves as such. For my purposes, this is how I prefer to be known as.
What are your pronouns?
I have recently begun to adopt they/them/their in a professional setting.
Why are they your pronouns?
Simple answer: I am tired of the aggressive misgendering.I am comfortable with my gender identity and I choose to express it in a way that makes me feel comfortable. Unfortunately, there are people in my daily life (some well-meaning, others not so much) that feel the need to "correct" other people or will not respect my identity as a non-binary person. I also would like to normalize the usage of they/them pronouns in a professional setting, which is extremely arrogant of me to want, but it is sorely needed in a vast majority of fields (not just the ones I'm in).
What should I call you?
Short answer: Whatever you know me as, just none of that Sir/Ma'am/Mr./Ms./Mrs./Miss/Mx. stuff.My name hasn't changed and I don't plan on changing it either. I like my name and will continue to introduce myself in whatever name fits the language I am speaking. If you knew me as 'Siobhan' before, I'm still 'Siobhan' now. Si vous me connaissez sous le nom de 'Renee,' je suis toujours 'Renee.' There's no deadname or preferred name, so don't worry about it. I would prefer if you didn't attach English honourifics to my name, でも日本の敬語は大丈夫ですよ.
Are you trans/non-binary/genderfluid/etc.?
Short answer: Yes (on a technical level).Non-conforming and non-binary are what I would use to describe my gender. On a technical level, these terms fall under the transgender umbrella. Depending on the language I'm speaking, I refer to myself using masculine, feminine, or neutral pronouns and end my sentences with various gendered endings, but this is more of a byproduct of me not being a native speaker than me intentionally choosing to speak in a certain way. I am who I want to be.Whether you believe that I am a woman, a man, a non-binary person, or something else entirely won't change the fact that I am me. I choose to see myself for who I am and I don't put much emphasis on how others perceive my existence as a person, though I would be grateful if you didn't assume what I am at first glance.
I think I accidentally misgendered you!
Acknowledge it and move on.If you catch yourself in a sentence using the wrong pronoun, just say "sorry" and backtrack + change the pronoun and move on. If you realize it after the conversation, just say "sorry" and move on. You are being self-aggrandizing if you hyperfocus on the mistake and continue to draw attention to it!
I used to know you as/still think of you as [insert gender here].
Just remember that I'm still the same person you knew back then. I'm just more open about myself now. I see myself for who I am and I don't need to justify my existence to anyone.I'm drawing a line with my interactions at work and in a professional setting and would prefer if you used they/them.
I have more questions, but I'm scared of asking you.
I promise you I'm not as scary as everyone says I am. I just look terrifying with my soulless gaze.Jokes aside, I'm always willing to have a discussion about my identity. I find that I am quite difficult to offend, and I am open to answering a lot of questions. Feel free to connect with me at any point to discuss it! I'm also very open about discussing your own personal identity journey, so please feel free to connect about that as well.
Skills
| Skills I Possess | Courses I Have Taken | Certifications | Languages I Speak |
|---|---|---|---|
| Project Management | CHY 330 - Atomic and Molecular Spectroscopy | safetalk | English (Native) |
| Team Management & Leadership | PHL 509 - Bioethics | Be There - Mental Health Support | Cantonese Chinese (Native) |
| Creative and Technical Writing | PEC 715 - Pharmacoeconomics | Health Canada Division 5 - Drugs For Clinical Trials Involving Human Subjects | Japanese (Intermediate) |
| Copyediting | MTH 500 - Introduction to Stochastic Processes | Good Clinical Practice (GCP) - Canada | Canadian French (Elementary) |
| Pharmaceutical and Cosmetic Product Formulation | PSY 607 - Drugs and Human Behaviour | Transportation of Dangerous Goods TDG/IATA course - Canada | |
| Computational Chemistry | PCR 901 - Introduction to Clinical Research | Take Home Naloxone | |
| Polymer Coatings | CHY 501 - Polymer Chemistry | Responsible Conduct of Research |
Academic CV
Education
Year & Location
Ontario College Graduate Certificate, Pharmaceutical Regulatory Affairs & Quality Operations - Seneca College
Concentrations: DEL, DIN-A, NDS, CTA Submissions; Technical Writing, Science Communication, Clinical Trial Ethics, ICH Guidelines
President's Honours List, Summer 2022
January 2022 - December 2022
Toronto, Ontario, Canada
Bachelor of Science (Honours), Chemistry -
Toronto Metropolitan University
Formerly known as Ryerson University.
Concentrations: Polymers and Computational Chemistry.
Minor: Mathematics (Stochastic Processes, Statistics, Discrete Maths, Graph Theory).
Undergraduate Dissertation Topic: Using Density Functional Theory (DFT) to study hypercoordination in a phosphine oxide polystannane precursor (Supervisor: Dr. R. Stephen Wylie).
September 2016 - June 2020
Toronto, Ontario, Canada
Experience
Year & Location
Graduate Research Assistant - University of Guelph
Researched electrolyte effects on electrochemical CO2 reduction.
Utilized VASP, Quantum ESPRESSO, Atomic Simulation Environment, BASH and Anaconda to create and run calculations.
Analyzed results using statistical methods and Python scripts.
Wrote review article summarizing progress and perspectives in electrochemical CO2 reduction.
Presented research at 23rd Annual Concordia Chemistry and biochemistry Graduate Research Conference, and won 1st place in Computational Chemistry category.
September 2020 - December 2020
Guelph, Ontario, Canada
Undergraduate Research Assistant - University of Guelph
Investigated binding sites on Al and Al-alloy surfaces.
Researched electrolyte effects on electrochemical CO2 reduction.
Utilized VASP, Quantum ESPRESSO, Atomic Simulation Environment, BASH and Anaconda to create and run calculations.
Analyzed results using statistical methods and Python scripts.
May 2020 - August 2020
Guelph, Ontario, Canada
Undergraduate Research Assistant - Toronto Metropolitan University
Member of the Advanced Synthetic Materials Lab, under the supervision of Dr. Daniel. A. Foucher.
Assisted in preparing and testing antimicrobial efficacy of UV-curable quaternary ammonium polymer coatings.
Coated various plastic and glass samples using spin, spray and electrospray coating techniques.
Counted colony growth of Arthrobacter sp. and E.coli wt36 after exposure to coatings.
Computed statistics and created graphs to communicate the test results and for publication.
Findings published in ACS Applied Bio Materials.
April 2019 - June 2020
Toronto, Ontario, Canada
Publications
Rachel L. Shum, Siobhan R. Liu, Alexander Caschera, and Daniel A. Foucher. UV-Curable Surface-Attached Antimicrobial Polymeric Onium Coatings: Designing Effective, Solvent-Resistant Coatings for Plastic Surfaces. ACS Applied Bio Materials, 2020. 3(7), 4302-4315. DOI: 10.1021/acsabm.0c00359
Conferences
48th Annual Southern Ontario Undergraduate Student Chemistry Conference - Siobhan R. Liu, R. Stephen Wylie. Density Functional Theory Analysis of Hypercoordinate Phosphine Oxide Containing Organotin (IV) Compounds. Toronto Metropolitan University, Toronto, ON, Canada. March 14, 2020
23rd Annual Chemistry and Biochemistry Graduate Research Conference - Siobhan R. Liu, Laura Martin, Mirna Ghattas, Leanne D. Chen. Effects of solvated ions on electrochemical CO2 reduction. Concordia University, Montreal, QC, Canada. November 23, 2020
Memberships
Chemical Institute of Canada - Graduate Student Member (2020 - 2021)
Out in STEM - Professional Member (2023 - Present)
Scholarships, Awards and Recognitions
Best Oral Presentation - Computational Chemistry; 23rd Annual Chemistry and Biochemistry Research Conference
Faculty of Science Dean's List 2019-2020; Toronto Metropolitan University
2016 Toronto Metropolitan Entrance Scholarship; Toronto Metropolitan University
Images
Esports CV
Experience
Year & Location
President - TMU Bold Esports
Third President of Ryerson/TMU Bold Esports and first non-male President of the club.
Assisted with forming the yearly operational budget alongside the VP Finance.
Headed meetings as the chairperson.
Oversaw the creation of the Rainbow 6: Siege and Super Smash Bros. Ultimate teams.
January 2019 - April 2020
Toronto, Ontario, Canada
Vice President - TMU Bold Esports
Created the executive club structure, consisting of a VP Finance, VP Internal Relations, VP External Relations, VP Events and VP Content.
Worked alongside the VP Finance to secure over $3000 worth of grant funding through the Students' Union's Competitive Athletics Club Grant programme.
Rewrote and amended the club constitution alongside the President.
Formed yearly operational budget alonsgide the VP Finance.
Established a system for bringing up and resolving conflicts and grievances within a competitive team alongside the VP Internal Relations.
Oversaw the creation of Fortnite and Smash Ultimate teams.
Organized bake sale fundraisers to assist teams with attending LANs.
Assisted with event planning and execution alongside the VP Events.
Collaborated with the Computer Science Course Union on a joint Mario Kart tournament and pub night.
Organized 2 jersey sales and jersey distribution to the club and members of the public.
Created and managed the club website.
May 2018 - January 2019
Toronto, Ontario, Canada
CS:GO Team Manager - TMU Bold Esports
Managed the varsity CounterStrike: Global Offensive team, consisting of 8 players and 2 coaches.
Counselled and provided academic and emotional support for all of my players and managers.
Organized team practice schedules, official matches and scrims.
Became a top 10 ranked collegiate CS:GO team for the 2017-2018 varsity season.
Winner of LANWarX 2018 ($700).
Top 8 in Collegiate Starleague 2018-2019 Season ($2000).
4th at Saints Gaming Live 2018.
September 2017 - January 2019
Toronto, Ontario, Canada
Media Appearances
Meet the women of Ryerson Esports - Jasmine Bala, The Ryersonian
For Ryerson Esports, virtual space is not enough - Marco Sasso, The Eyeopener
Professional CV
Experience
Project Management Associate - Probity Medical Research Inc.
Year & Location
August 2024 - Present
Waterloo, Ontario, Canada
Project Management Assistant - Probity Medical Research Inc.
Assisted with managing regulatory aspects for clinical trials across 60+ contract research clinics in 3 countries (Canada, USA, Australia).
Maintain and organize all internal and external correspondences and regulatory files in company's file retention system.
Liaise with study sponsors and trial sites to start up studies in a timely manner.
Draft and manage research ethics board applications for studies by reporting applicable events and annual study reviews.
Organize and submit regulatory paperwork for study startup and closure.
August 2023 - August 2024
Waterloo, Ontario, Canada
Compliance Assistant - Probity Medical Research Inc.
Compile regulatory reports, compliance summaries, serious adverse events and protocol deviation reports; study summaries, and inspection checklists for 60+ trial sites within the research network for use during inspections and audits conducted by Health Canada, US FDA, EMA, and other regulatory bodies.
Maintain and organize all internal and external correspondences and regulatory files in company's file retention system.
Provide support to trial sites during regulatory inspections and audits, advising on measures to implement to correct for inspection findings that are brought up or discovered.
Assist with drafting responses to regulatory bodies for unclosed inspection findings.
Actively maintain training and working knowledge in ICH Good Clinical Practices; Health Canada Regulations, Part C, Division 5; and Title 21 of the CFR.
Assist with key performance indicator analysis of trial startup times from study feasibility to site startup.
January 2023 - August 2023
Waterloo, Ontario, Canada
Regulatory Affairs Intern - Reckitt Health (Canada)
Organize and archive historic regulatory submission documents in validated digital file repository (CARA).
Upload and maintain current regulatory submission documents in CARA.
Assist with CAPA write-up on CARA to close out internal audit.
Validate and manage regulatory submissions and product formulations within dossier management system (GRAIS).
Localize global regulatory manufacturing records for recently-acquired Biofreeze products.
Review cosmetics, drug products, medical devices, and natural health products branding to ensure compliance with Health Canada regulations.
Review and summarize new Health Canada guidance documents on labelling changes to natural health products.
Create a cosmetic notification to Health Canada for upcoming Veet NPDs/EPDs launching in Q1 2023.
June 2022 - August 2022
Kanata/Mississauga, Ontario, Canada
COVID-19 Representative and Laboratory Assistant - Maple Leaf Foods
Screened employees and visitors daily for signs and symptoms of COVID-19.
Conducted layered process audits on employees following company COVID-19 protocols.
Chaired biweekly company COVID-19 meetings.
Assisted in chemistry sample preparation and disposal.
Assisted in microbiology sample disposal.
Spearheaded and organized data transfer from archived internal shared drives to Microsoft Sharepoint.
Assisted in writing technical SOPs for method validations.
Planned, researched, and conducted method validation research project on protein coagulation in cooked and uncooked meat products.
August 2021 - December 2021
Guelph, Ontario, Canada
Editor and Writer - MyAnimeList
Editor and writer for MALRewrite.
Rewrite existing anime and manga summaries to meet MyAnimeList's style guidelines.
Edit written synopses by other volunteers for correct spelling, grammar, punctuation, syntax, diction, tensing, and conent.
Writer of the Month for August 2021.
March 2021 - Present
Shinjuku-ku, Tokyo, Japan
Circulation Desk Assistant - Toronto Metropolitan University
Career Boost position for the Toronto Metropolitan Library and Archives.
Conducted floor counts to check for seating capacity and overall patron safety.
Assisted with checking in and out, sorting and re-shelving library materials.
Troubleshooted printing and other technical problems within the Library's computer labs.
Reported and created cleaning tickets with Facilities Management and Development (FMD) when required.
Provide assistance and directions to patrons and other community members asking for information.
September 2019 - April 2020
Toronto, Ontario, Canada
Ceremonials Assistant - Toronto Metropolitan University
Career Boost position for the Ceremonials Office under the Office of the President.
Answered daily phone calls and emails inquiring about Convocation.
Provided technical support for the Convocation RSVP system.
Created an organizational process for university's academic regalia.
Assisted with coordinating vendors during event setup and takedown.
Managed and lead a team of 30+ student staff and 200+ volunteers every convocation period.
Lead the graduand sign in team and provided on-site live technical support for registration.
Assisted with graduand and faculty gowning and hooding.
Coordinated graduand regalia return and preparation for the next ceremony.
Compiled and analyzed ceremony statistics to make better predictions for future ceremonies.
Take inventory of event supplies and academic regalia before and after every convocation period.
Advanced Placement Exam Proctor -
Upper Grand District School Board
Set up and maintained examination room according to The College Board's standards.
Distributed and collected exam materials.
Maintained academic integrity of the examinations.
May 2017
Guelph, Ontario, Canada
Contact
Need to contact me? Shoot me an email by filling out the form or a LinkedIn PM by clicking the icon below! Check out my ORCID for my publications. Click on the MAL icon to view my writing contributions to the MAL Rewrite project and the paintbrush to view my writing portfolio.References available upon request.